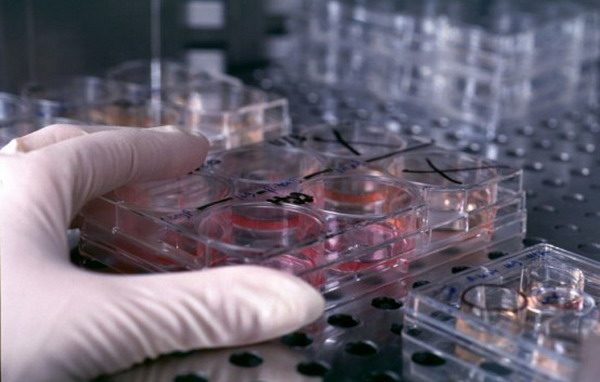
Dibattito sulle staminali: <br>terapia, speranza o illusione?

Categoria: Tutte le notizie
Paritarie: gli stessi diritti a tutti i bambini
I rappresentanti delle associazioni impegnate nel settore: occorre garantire la continuità del servizio
«Cari ragazzi, sappiate prendervi
il presente»
Scola ha invitato ragazzi, adulti, educatori e chi ha responsabilità della cosa pubblica a costruire «creativamente la società di domani»
«Uomo di grande equilibrio
anche in tempi difficili»
Monsignor Gianni Zappa, presidente del Comitato organizzativo, traccia un bilancio sull’Anno Colombiano
Un pellegrinaggio in Terra Santa
per gli insegnanti
Servizio Irc e Pastorale scolastica della Diocesi organizzano il viaggio «nella terra del Santo». Iscrizioni aperte fino alla fine di ottobre
Nei Decanati gli incontri di spiritualità
per persone impegnate nel socio-politico
A fare da guida il brano del Vangelo di Luca che narra della predicazione di Giovanni Battista e del suo invito a convertirsi
Lurago d’Erba festeggia i 100 anni
di San Giovanni Evangelista
Settimana di eventi in onore del centenario della chiesa consacrata dal cardinale Ferrari conclusi dalla messa presieduta dal cardinale Versaldi, presidente della Prefettura degli Affari economici della Santa Sede
Scola in Francia per parlare
di nuova evangelizzazione
A Le Mans il Cardinale parteciperà alle Giornate promosse dall’associazione «Essentiel’Mans» sulle nuove sfide dell’evangelizzazione, a 50 anni dal Concilio. A Parigi presentazione di due suoi libri
Gli oratori lombardi:
«Contiamoci e conosciamoci»
Don Samuele Marelli illustra l'indagine curata dall’Istituto Ipsos di Milano per conto di Odielle, con cui si raccoglieranno i dati sui numeri e sulle attività. Compilazione entro il 5 novembre
Dibattito sulle staminali:
terapia, speranza o illusione?
Convegno di bioetica promosso dalla Pastorale diocesana della salute all’auditorium di via S. Antonio 5
Il parroco di Lampedusa a Barzanò
Don Stefano Nastasi invitato dal parroco don Giuseppe Scattolin a portare la sua testimonianza ai fedeli della Comunità pastorale SS Nome di Maria, che comprende anche le parrocchie di Cremella e Sirtori
La lezione del Vajont
brucia ancora 50 anni dopo
Distruzione e morte. Solidarietà e rinascita. In questo orizzonte si colloca il disastro della diga che costò 1910 vite e cancellò Longarone. Un monumento alla memoria che in queste ultime settimane ha visto aggiungersi, a tante altre sue componenti, anche quelle delle scuse formali di esponenti del governo, ma anche di ordini professionali, come i geologi, che hanno pubblicamente riconosciuto gli errori compiuti in passato
Da Nazareth a Gerusalemme,
2000 anni dopo
Una suggestiva mostra fotografica di Paolo Miramondi esposta a Milano presso la Libreria Terra Santa.
Giovani a Seveso
per “un incontro che cambia la vita”
Nell’ambito delle “Vie incontro all'umano” un week-end residenziale rivolto a chi desidera meditare sul rapporto con Gesù e sul nuovo sguardo che da esso può nascere
La Chiesa di Milano accoglie gli universitari
«Lasciamoci sorprendere da Dio» è il titolo della veglia di preghiera alle 20.45 presso la Basilica di San Lorenzo, rivolta in particolare agli studenti fuori sede
«La Missione ha scaldato il cuore
a tutti, preti e laici»
Bilancio molto positivo dell’esperienza vocazionale che ha visto 58 seminaristi a contatto con famiglie, scuole e realtà della località brianzola: «Hanno portato una ventata di freschezza e l’immagine di un Seminario al passo coi tempi»
Tra Terra e Cielo: così l’arte
aiuta le vittime della guerra in Siria
Una mostra-mercato dei quadri di Pier Luca Bencini, ideata in collaborazione con le suore trappiste di Valserena, il cui ricavato sarà interamente devoluto alla popolazione martoriata di Aleppo. Inaugurazione mercoledì 10 ottobre, alle ore 18.30, alla presenza di mons. Giuseppe Nazzaro, già Vicario Apostolico di Aleppo.
Scola e i preti di Lecco,
dialogo sulla dimensione degli affetti
È uno dei temi affrontati nell’incontro tra l’Arcivescovo e i sacerdoti della Zona III, svoltosi a Eupilio, di cui parla il Vicario episcopale monsignor Rolla
I futuri paralimpici in vetrina
Nell’ambito di Reatech convegno con giovani atleti disabili che, accompagnati da atleti olimpici e paralimpici, si confronteranno col pubblico sulle loro esperienze sportive e di vita
Una Messa al Santuario degli Sportivi
Alle 18 al Centro Schuster, presieduta dal vicario episcopale monsignor Pierantonio Tremolada
Basta con gli applausi:
ridateci il silenzio…
Il minuto di silenzio è oggi un minuto violato, violentato, tradito, calpestato. È un intruso da emarginare, un imbarazzo da superare, un nemico da aggirare con la banalità di un applauso